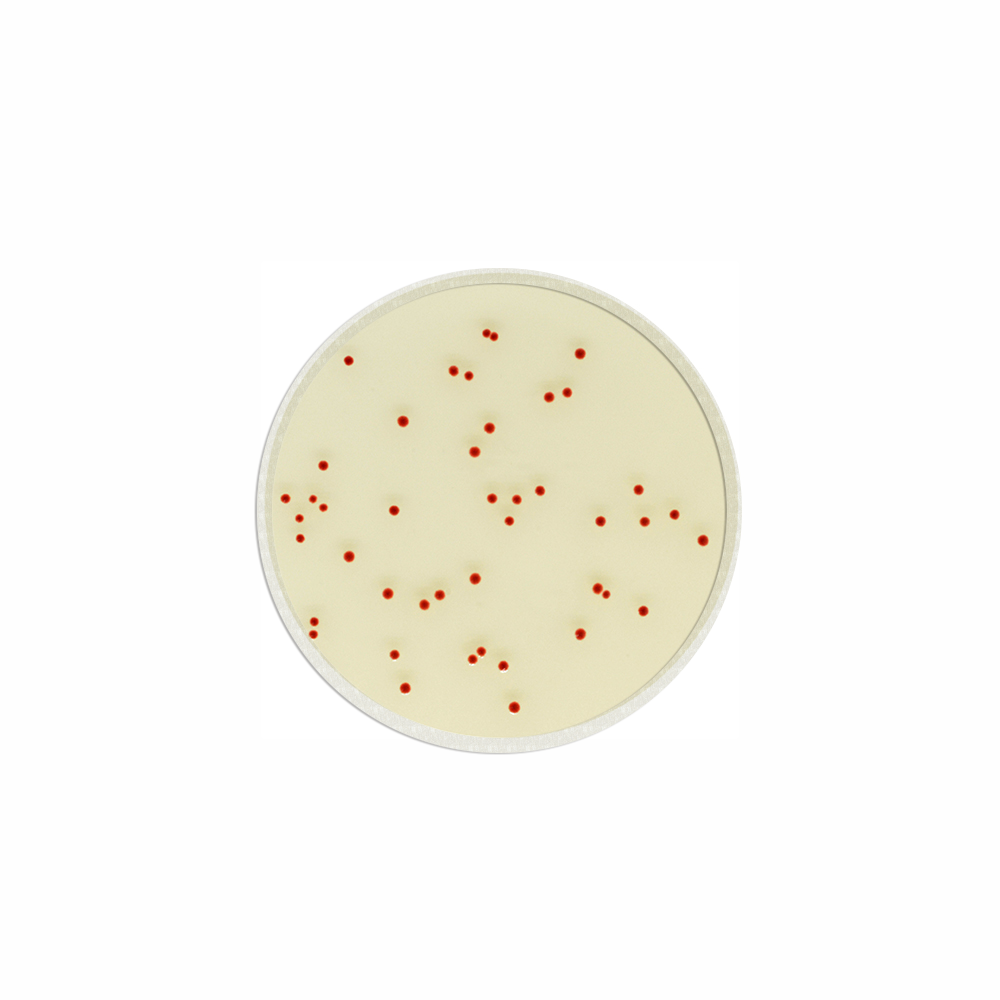

Über das Produkt
Chromogenes Medium zur Detektion, Differenzierung und Zellzahlbestimmung von thermotoleranten Campylobacter Spezies nach ISO 10272-1.
CHROMagar Campylobacter Fertigplatten
Chromogenes Medium zur Detektion, Differenzierung und Zellzahlbestimmung von thermotoleranten Campylobacter Spezies nach ISO 10272-1.